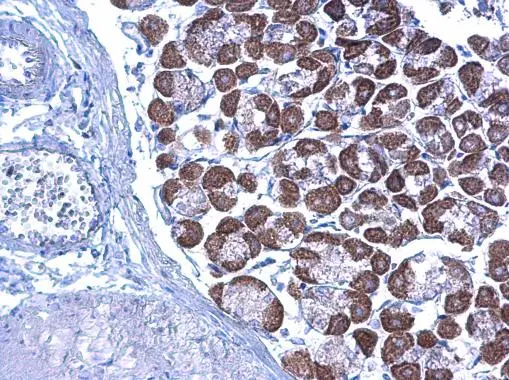
LETM1 antibody detects LETM1 protein at cytoplasm on mouse stomach by immunohistochemical analysis. Sample: Paraffin-embedded mouse stomach. LETM1 antibody (GTX112455) diluted at 1:500. 
 Antigen Retrieval: Trilogy? (EDTA based, pH 8.0) buffer, 15min

Anti-LETM1 Antibody
144-61151
ApplicationsWestern Blot
Product group Antibodies
ReactivityHuman, Mouse, Rat
TargetLETM1
Overview
- SupplierRayBiotech
- Product NameAnti-LETM1 Antibody
- Delivery Days Customer16
- ApplicationsWestern Blot
- CertificationResearch Use Only
- ClonalityPolyclonal
- ConjugateUnconjugated
- Gene ID3954
- Target nameLETM1
- Target descriptionleucine zipper and EF-hand containing transmembrane protein 1
- Target synonymsCONDMIM, KHE, Mdm38, SLC55A1, mitochondrial proton/calcium exchanger protein, LETM1 and EF-hand domain-containing protein 1, mitochondrial, Mdm38 homolog, electroneutral mitochondrial K(+)/H(+)exchanger, leucine zipper-EF-hand containing transmembrane protein 1
- HostRabbit
- IsotypeIgG
- Protein IDO95202
- Protein NameMitochondrial proton/calcium exchanger protein
- Scientific DescriptionLETM1 Polyclonal Antibody
- ReactivityHuman, Mouse, Rat
- Storage Instruction-20°C
- UNSPSC12352203